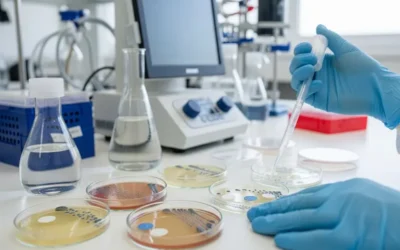
Resistencia a los Antibióticos: OMS alerta sobre incremento a nivel mundial

Suplementos Vitamínicos para Niños: ¿Qué Dice la Ciencia?
La Dieta Equilibrada es la Base, la Suplementación es la Excepción La pregunta sobre si los niños necesitan suplementos vitamínicos es una de las...
La Ciencia de la Respiración Anal: De broma IgNobel a salvavidas
Lo que hace apenas un año parecía una broma científica destinada a arrancar carcajadas, al ganar el premio IgNobel de Fisiología en 2024, hoy se...
Riesgo oculto en la cirugía de mamas: La evaluación oncológica previa
En el mes de la concientización sobre el cáncer de mama, surge un tema de vital importancia: el riesgo oculto en la cirugía de aumento o...
Té Matcha: el tesoro verde de Japón, más que una bebida
Té Matcha: El secreto verde de Japón para la energía, calma y antioxidantes. ¿Qué dice la ciencia? ¡Sigue leyendo!
Ejercicio y Osteoporosis: Fortaleciendo Huesos y Calidad de Vida
Ejercicio y Osteoporosis: La ciencia confirma que el movimiento es clave para huesos fuertes y prevenir fracturas. ¡Sigue leyendo!
Ejercicio aeróbico y de fortalecimiento: El mejor aliado contra el dolor de rodilla
Durante mucho tiempo, el dolor de rodilla, a menudo causado por la osteoartritis (artrosis), se abordó con la creencia de que el reposo era la mejor...
Secreto francés para una piel de ensueño: El poder del colágeno marino
La belleza atemporal de las mujeres francesas a menudo se atribuye a una combinación de hábitos de cuidado sutiles pero efectivos. Uno de sus...
Florecer en Rosa: La campaña que transforma la prevención del cáncer en amor propio
Octubre es el mes de la concientización sobre el cáncer de mama a nivel mundial, y la Sociedad Anticancerosa de Venezuela (SAV) lanza la campaña...
Blefaritis y pestañas postizas: Riesgos y prevención ocular
La salud de nuestros ojos depende directamente de la salud de nuestros párpados. Un trastorno común, pero a menudo crónico, es la blefaritis, una...
Uveítis o Inflamación de la Úvea: Una Amenaza para la Visión
La inflamación de esta zona puede dañar el tejido ocular esencial y, si no se trata a tiempo, provoca una pérdida de visión grave y permanente La...
Resistencia a los Antibióticos: OMS alerta sobre incremento a nivel mundial
Alerta OMS: La resistencia a antibióticos amenaza la salud global. Entiende la crisis y cómo detenerla. ¡Sigue leyendo!
Betaína: el poder oculto de la remolacha para tu cuerpo
Descubre la Betaína, el compuesto estrella de la remolacha que potencia tu corazón, hígado y energía. ¡Sigue leyendo!
Combate el estreñimiento crónico: Alimentos que tu intestino amará
El estreñimiento crónico es una condición incómoda y persistente que afecta la calidad de vida de millones de personas. Se define generalmente por...
Anatomía facial: la base de la seguridad estética
La Medicina Estética y la Cirugía Plástica exigen una formación continua, y el conocimiento profundo de la anatomía facial es tu principal garantía...
Trombosis Venosa: la obstrucción peligrosa en el flujo sanguíneo
Trombosis Venosa: ¿Sabes qué es un coágulo y sus peligros? Reconoce los síntomas y protégete. ¡Sigue leyendo!
Un apoyo vital contra el cáncer de mama
La fundación "Senos Ayuda" lleva diecinueve años actuando como un "pecho solidario" para las mujeres venezolanas afectadas por el cáncer de mama. Su...
Detección a tiempo: la clave contra el cáncer de mama
El mes de concienciación sobre el cáncer de mama busca recalcar una verdad vital: el diagnóstico temprano eleva drásticamente tu tasa de...
Vacuna contra el Herpes Zóster: una defensa clave ante el dolor
Protección Frente a una Enfermedad Dolorosa y Complicada El herpes zóster, comúnmente conocido como culebrilla, es una infección viral causada por...